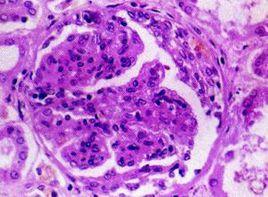
血清抗GBM抗體陽性 血清抗GBM抗體陽性

原因
血清抗GBM抗體陽性的病因
確切病因不清,可能為多種病因共同作用的結果,一般認為與以下因素有關:
1.感染呼吸道感染,特別與流感病毒感染是本病最常見的誘因,最近研究發現獲得性免疫缺陷病患者感染卡氏肺囊蟲肺炎(PneumocystisCariniiPneumonia)後,機體易產生抗GBM抗體,Calderon等報導4例HIV感染者中3例抗Ⅳ型膠原alpha;3鏈抗體(抗GBM抗體)陽性,提示卡氏肺囊蟲肺炎時肺泡損害可以誘發肺出血-腎炎綜合徵。
2.接觸汽油蒸汽,羥化物,松節油及吸入各種碳氫化合物。
3.吸入古柯鹼Perez等報導1例長期吸菸的患者在吸用古柯鹼3周以後發生了肺出血-腎炎綜合徵。
檢查
血清抗GBM抗體陽性的檢查診斷
本病可發生於任何年齡,但多為20~30歲的男性青年,患者一般表現除非合併感冒,多無發熱,常有疲乏,無力,體重下降等,其臨床特徵性表現為三聯征:肺出血,急進性腎小球腎炎和血清抗GBM抗體陽性。
1.肺出血典型患者除非合併感染,一般無發熱,肺部最重要的表現為咯血,約49%的患者咯血為首發症狀,從咯血絲至大咯血不等,重症(尤其吸菸者)大咯血不止甚至窒息死亡,患者多伴氣促,咳嗽氣喘,呼吸困難,有時有胸痛症狀,肺部叩診呈濁音,聽診可聞濕?音,肺CO攝取率(Kco)為早期而敏感的肺功能改變指示,在腎衰及肺水腫患者該值下降,而肺出血時此值上升。
一般肺部症狀可先於腎臟表現數天,數周,或數年出現,肺部出血可輕可重,也可嚴重至危及生命,大量或持續出血可發生缺鐵性貧血,一旦出現胸痛,應注意排除系統性紅斑狼瘡,血管炎或肺栓塞等病變,肺部X線顯示彌散性點狀浸潤陰影,從肺門向外周散射,肺尖常清晰,咯血和肺部浸潤是肺部病變的特徵。
2.腎臟病變腎臟病變的臨床表現多樣,輕度腎小球損害者,尿液分析和腎功能可正常,臨床主要表現為反覆咯血,腎活檢仍然可顯示典型的抗基膜抗體線狀沉積的免疫學特徵,典型患者腎功能損害發展較快,有少尿或無尿者,血清肌酐濃度逐日升高,於3~4天內達到尿毒症水平;無少尿者,腎臟損害常為急進性發展,血清肌酐濃度每周升高,數月內發展至尿毒症,大多數患者其特徵性表現是進行性腎功能損害,據統計,81%患者於1年內發展為腎功能衰竭,血壓正常或輕度升高,尿液分析呈現血尿和蛋白尿,常有紅細胞管型,少數患者有大量蛋白尿及腎病綜合徵。
3.特殊表現
(1)肺出血-腎炎綜合徵向其它病理類型的腎小球疾病轉化:Elder等報導1例患者有典型的肺-腎臟病理表現與臨床表現,腎功能保持良好,血清與組織抗GBM抗體呈陽性,顯著缺鐵性貧血,免疫抑制治療後貧血改善,血清抗GBM抗體消失,9個月後發生了腎病綜合徵,腎活檢複查顯示膜性腎病不伴抗GBM抗體腎內沉積。
(2)其他病理類型的腎小球疾病向肺出血-腎炎綜合徵轉化:Thitiarchakul報導1例特發性膜性腎病患者,病程中腎功能急性惡化,伴有咯血,嚴重高血壓及血清抗GBM抗體陽性,腎組織檢查顯示典型抗GBM免疫病理表現,使用大劑量激素,CTX及血漿置換無效。
(3)肺出血-腎炎綜合徵只局限於肺或腎一個器官:Patron等報導1例單純性肺出血-腎炎綜合徵,Perez等報導1例古柯鹼誘發的肺出血-腎炎綜合徵,只有典型腎臟改變,肺泡基膜沒有IgG及C3呈線樣沉積,其他如抗基底膜抗體結合於脈絡膜,眼,耳,偶可引起相應的表現,如眼底出血及滲出,其發生率可高達11%,可能是急劇發展的高血壓所至。
診斷
1.肺出血-腎炎綜合徵的診斷關鍵是確定機體有無抗GBM-肺泡基膜自身體液免疫過程,存在該過程的特徵性表現:
(1)血清抗GBM抗體陽性。
(2)肺泡及腎臟基膜有IgG呈線樣沉積。
2.典型患者的診斷完全符合下列三聯征
(1)肺出血,肺泡基膜IgG呈線樣沉積。
(2)急進性腎炎綜合徵,腎臟大量新月體形成(毛細血管外增生性腎炎),可伴毛細血管壞死,GBM有IgG呈線樣沉積。
(3)血清抗GBM抗體陽性。
3.肺出血-腎炎綜合徵診斷的注意事項
(1)有些患者肺和(或)腎臟的表現輕微,或者兩個臟器不同步發生病變,有時抗基膜自身免疫過程只發生於肺或腎臟中的任一臟器。
(2)抗GBM腎炎與其他類型的腎小球疾病(主要是膜性腎病)之間有時可相互轉變(見臨床表現)。
(3)偶爾自身免疫功能紊亂會產生非特異性基膜抗體,還可引起肺腎以外的器官損害。
(4)個別情況下如自身免疫高度活動期,大量抗GBM抗體沉積,可發生一過性血清抗GBM抗體陰性,有報導1例有典型的肺出血-腎炎綜合徵腎臟臨床與病理表現的患者,同時伴有肺部損害,血清抗GBM抗體陰性,他認為這可能是由於高度活動期間抗體在靶器官內大量沉積所致。
(5)肺出血-腎炎綜合徵與血管炎並存,Rydel等報導1例18歲的男性肺出血-腎炎綜合徵患者,在進行血漿置換及使用細胞毒性藥物過程中發生難治性癲癇,MRI顯示多發性腔隙性腦梗死(MultipleLacunarInfarcts),腦脊髓膜活檢顯示血管炎,但血清ANCA持續陰性,給予大劑量皮質激素及細胞毒性藥物後,再使用抗癲癇藥可症狀控制,Kalluri等報導1例結節性肺部浸潤與急性腎衰竭患者,c-ANCA陽性,腎臟組織檢查顯示新月體性及壞死性腎炎,IgG及C3在腎小球內線樣沉積,血清有高滴度抗GBM-IgG。
鑑別診斷
血清抗GBM抗體陽性易混淆的症狀
肺出血-腎炎綜合徵的主要表現是肺腎綜合徵及急進性腎炎,所以本病需與以這兩種表現為主的多種疾病相鑑別。
1.肺腎綜合徵可引起肺腎綜合徵的疾病除了肺出血-腎炎綜合徵之外還有多種,如ANCA相關性系統性血管炎、SLE及感染引起的腎炎。此外,腎靜脈血栓所致的肺栓塞、終末期腎衰所致的充血性心力衰竭也可發生咯血。Ent等報導2例兒童患者,免疫複合物沉積同時引起肺出血與腎小球腎炎。Hernandez報導1例特發性細支氣管閉塞(IdiopathicBronchiolitisObliterans)患者發生了急進性腎炎,組織學檢查在肺和腎內都發生了大量IgA沉積。
免疫複合物腎炎時腎小球毛細血管有顆粒樣沉積,電鏡檢查可見電子緻密物,血清抗GBM抗體陰性,而循環免疫複合物可陽性,與肺出血-腎炎綜合徵區別不難。
2.狼瘡性腎炎此病患者表現急進性腎炎時,可出現急性腎功能衰竭伴肺出血症狀,易與肺出血-腎炎綜合徵混淆。但該病多見年青女性,一般有皮膚、關節等全身多系統損害,血清免疫學檢查可助診斷。
3.小血管炎腎炎此類疾病可有肺出血表現而近似肺出血-腎炎綜合徵。但該病多見於50~70歲中老年人,有乏力、低熱、體重下降等全身症狀明顯,血抗中性粒細胞胞質抗體(antibodiestoneutrophileytoplasmicantigens,ANCA)陽性。其中韋格納肉芽腫者可呈間質性炎症,兩者偶可同時存在。
在許多血管炎中,小血管炎有兩種即Wegener肉芽腫及鏡下多血管炎,這兩種小血管炎其靶抗原分別為蛋白酶3(Proteinase3)及髓過氧化酶(Myeloperoxidase,相應的抗體(c-ANCA及p-ANCA)是引起小血管損害的原罪抗原,對小血管炎具有重要診斷價值。在Wegener肉芽腫及鏡下多血管炎時,上下呼吸道及腎臟最常受累。Wegener肉芽腫的形態學改變多種多樣,在口咽、鼻旁竇、氣管等處主要表現為潰瘍性變化,而肉芽腫樣變可有可無。所以,組織學檢查,尤其是小塊活組織檢查時,不能輕易排除Wegener肉芽腫之診斷。Wegener肉芽腫及鏡下多血管炎在腎臟可表現為局灶性節段性壞死性腎小球腎炎,常伴有新月體形成,腎小球內免疫沉積罕見。
4.急性腎炎伴左心衰竭此病可有血痰及呼吸困難表現,與肺出血-腎炎綜合徵類似,但該病多見於青少年患者。多有鏈球菌感染史,常因嚴重高血壓、水鈉瀦留而產生水腫、充血性心力衰竭。腎活體病理檢查可資鑑別。
5.急進性腎炎急進性腎炎(新月體性腎炎)的免疫發病機制除了抗GBM腎炎外,免疫複合物腎炎及細胞免疫性血管炎也可引起典型的新月體腎炎及急進性腎衰竭。
6.特發性肺含鐵血黃素沉著症此病的咯血、痰中含鐵血黃素細胞及肺部X線表現都極似肺出血-腎炎綜合徵。但此病多發生於16歲以下的青少年,病情進展緩慢,預後好,肺及腎活檢可助鑑別。
本病可發生於任何年齡,但多為20~30歲的男性青年,患者一般表現除非合併感冒,多無發熱,常有疲乏,無力,體重下降等,其臨床特徵性表現為三聯征:肺出血,急進性腎小球腎炎和血清抗GBM抗體陽性。
1.肺出血典型患者除非合併感染,一般無發熱,肺部最重要的表現為咯血,約49%的患者咯血為首發症狀,從咯血絲至大咯血不等,重症(尤其吸菸者)大咯血不止甚至窒息死亡,患者多伴氣促,咳嗽氣喘,呼吸困難,有時有胸痛症狀,肺部叩診呈濁音,聽診可聞濕?音,肺CO攝取率(Kco)為早期而敏感的肺功能改變指示,在腎衰及肺水腫患者該值下降,而肺出血時此值上升。
一般肺部症狀可先於腎臟表現數天,數周,或數年出現,肺部出血可輕可重,也可嚴重至危及生命,大量或持續出血可發生缺鐵性貧血,一旦出現胸痛,應注意排除系統性紅斑狼瘡,血管炎或肺栓塞等病變,肺部X線顯示彌散性點狀浸潤陰影,從肺門向外周散射,肺尖常清晰,咯血和肺部浸潤是肺部病變的特徵。
2.腎臟病變腎臟病變的臨床表現多樣,輕度腎小球損害者,尿液分析和腎功能可正常,臨床主要表現為反覆咯血,腎活檢仍然可顯示典型的抗基膜抗體線狀沉積的免疫學特徵,典型患者腎功能損害發展較快,有少尿或無尿者,血清肌酐濃度逐日升高,於3~4天內達到尿毒症水平;無少尿者,腎臟損害常為急進性發展,血清肌酐濃度每周升高,數月內發展至尿毒症,大多數患者其特徵性表現是進行性腎功能損害,據統計,81%患者於1年內發展為腎功能衰竭,血壓正常或輕度升高,尿液分析呈現血尿和蛋白尿,常有紅細胞管型,少數患者有大量蛋白尿及腎病綜合徵。
3.特殊表現
(1)肺出血-腎炎綜合徵向其它病理類型的腎小球疾病轉化:Elder等報導1例患者有典型的肺-腎臟病理表現與臨床表現,腎功能保持良好,血清與組織抗GBM抗體呈陽性,顯著缺鐵性貧血,免疫抑制治療後貧血改善,血清抗GBM抗體消失,9個月後發生了腎病綜合徵,腎活檢複查顯示膜性腎病不伴抗GBM抗體腎內沉積。
(2)其他病理類型的腎小球疾病向肺出血-腎炎綜合徵轉化:Thitiarchakul報導1例特發性膜性腎病患者,病程中腎功能急性惡化,伴有咯血,嚴重高血壓及血清抗GBM抗體陽性,腎組織檢查顯示典型抗GBM免疫病理表現,使用大劑量激素,CTX及血漿置換無效。
(3)肺出血-腎炎綜合徵只局限於肺或腎一個器官:Patron等報導1例單純性肺出血-腎炎綜合徵,Perez等報導1例古柯鹼誘發的肺出血-腎炎綜合徵,只有典型腎臟改變,肺泡基膜沒有IgG及C3呈線樣沉積,其他如抗基底膜抗體結合於脈絡膜,眼,耳,偶可引起相應的表現,如眼底出血及滲出,其發生率可高達11%,可能是急劇發展的高血壓所至。
診斷
1.肺出血-腎炎綜合徵的診斷關鍵是確定機體有無抗GBM-肺泡基膜自身體液免疫過程,存在該過程的特徵性表現:
(1)血清抗GBM抗體陽性。
(2)肺泡及腎臟基膜有IgG呈線樣沉積。
2.典型患者的診斷完全符合下列三聯征
(1)肺出血,肺泡基膜IgG呈線樣沉積。
(2)急進性腎炎綜合徵,腎臟大量新月體形成(毛細血管外增生性腎炎),可伴毛細血管壞死,GBM有IgG呈線樣沉積。
(3)血清抗GBM抗體陽性。
3.肺出血-腎炎綜合徵診斷的注意事項
(1)有些患者肺和(或)腎臟的表現輕微,或者兩個臟器不同步發生病變,有時抗基膜自身免疫過程只發生於肺或腎臟中的任一臟器。
(2)抗GBM腎炎與其他類型的腎小球疾病(主要是膜性腎病)之間有時可相互轉變(見臨床表現)。
(3)偶爾自身免疫功能紊亂會產生非特異性基膜抗體,還可引起肺腎以外的器官損害。
(4)個別情況下如自身免疫高度活動期,大量抗GBM抗體沉積,可發生一過性血清抗GBM抗體陰性,有報導1例有典型的肺出血-腎炎綜合徵腎臟臨床與病理表現的患者,同時伴有肺部損害,血清抗GBM抗體陰性,他認為這可能是由於高度活動期間抗體在靶器官內大量沉積所致。
(5)肺出血-腎炎綜合徵與血管炎並存,Rydel等報導1例18歲的男性肺出血-腎炎綜合徵患者,在進行血漿置換及使用細胞毒性藥物過程中發生難治性癲癇,MRI顯示多發性腔隙性腦梗死(MultipleLacunarInfarcts),腦脊髓膜活檢顯示血管炎,但血清ANCA持續陰性,給予大劑量皮質激素及細胞毒性藥物後,再使用抗癲癇藥可症狀控制,Kalluri等報導1例結節性肺部浸潤與急性腎衰竭患者,c-ANCA陽性,腎臟組織檢查顯示新月體性及壞死性腎炎,IgG及C3在腎小球內線樣沉積,血清有高滴度抗GBM-IgG。
緩解方法
血清抗GBM抗體陽性的預防方法
Goodpasture綜合徵可迅速致死.死亡原因常為肺出血和呼吸衰竭,在急性期常需氣管插管,輔助通氣和血透.隨後的處理依賴於大劑量皮質類固醇的使用(甲基強的松龍每日7~15mg/kg,分次靜脈注射),免疫抑制劑環磷醯胺及反覆血透排除循環中抗腎小球基膜抗體.免疫抑制治療的療程變動較大,在某些病人則可能需要12~18個月.早期綜合使用這些措施可保護腎功能,晚期腎疾病可行長期血透或腎移植。